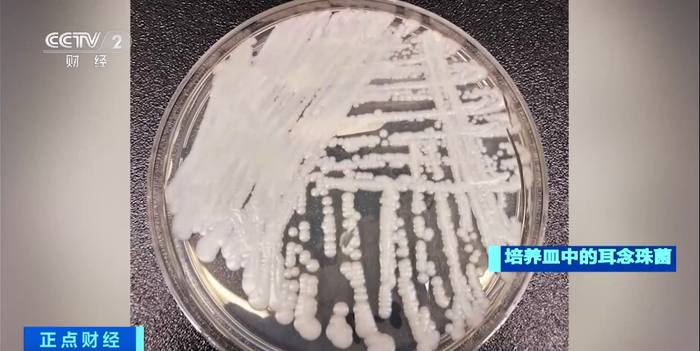

据美联社报道,美国疾病控制与预防中心当地时间20日发布报告称,一种名叫“耳念珠菌”的超级真菌正在以“惊人的速度”传播, 目前全美一半以上的州都报告了确诊病例。
据美国疾控中心介绍,耳念珠菌主要威胁群体是免疫系统较弱的老年人,具有高传染性,并且对于常见的抗真菌药物具备耐药性,容易在医院和老人护理机构等地方传播,可导致重症患者死亡。目前缺少特效的治疗药物。美国最早于2016年发现第一例确诊病例,目前已遍布美国一半以上的州。据报道,目前全美有三分之一的感染者因为这种真菌死亡。
美国疾控中心的研究人员称,新冠疫情很可能加剧了耳念珠菌的传播。因为随着公共卫生部门对新冠病毒的关注度提升,导致对耳念珠菌筛查的重视程度降低。此外,耳念珠菌容易附着在护理服、手套和其他个人防护装备上。由于疫情期间供应短缺,这些装备经常被重复使用,可能也加速了这个“超级真菌”的传播。
耳念珠菌,学名耳道假丝酵母菌。2009年在日本一位患者的外耳道中首次被发现,后来在血液、尿液、呼吸道等部位都有发现。
专家表示,尽管耳念珠菌传染性强,对于有正常免疫力的健康人群而言,发生这种感染的风险明显降低。 他们呼吁医院应加强防控,包括更新检测设备,提高检测手段,严格消毒流程。对发现耳念珠菌感染病例的医院,建议使用氯化物进行接触预防和有效消毒。